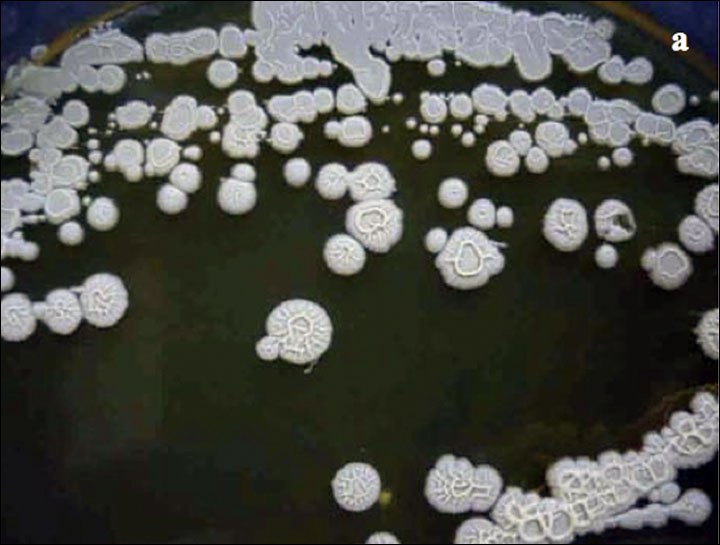
3.jpg

350만 년전 박테리아를 직접 넣은 과학자에게 생긴 일
박테리아

고대 박테리아를 발견한 러시아의 한 과학자가 영원한 생명을 얻기 위해 고대 박테리아를 몸에 투여했다고 합니다. 350만 년전 박테리아를 직접 넣은 과학자에게 생긴 일에 대해 소개해드리겠습니다.

러시아 연방 사하 공화국에 위치한 맘모스 산이라는 곳에서 고대 박테리아가 발견되었다고 합니다. 맘모스 산은 동토층으로 지금으로부터 350만 년전의 지층으로 맘모스 산 동토층에서 발견된 박테리아는 아직까지도 살아 있는 상태였다고 합니다.

이 박테리아를 발견한 러시아 과학자들은 몇 년에 걸쳐 실험쥐와 식물에 투여하는 실험을 계속했고 박테리아가 투여된 실험쥐는 보통 폐사하는 나이대에서 출산을 반복 할 정도의 저항력을 갖췄다고 합니다. 박테리아가 투여된 식물 역시 성장이 빨라지고 강해지는 등 몇 가지 변화를 보여주었다고 하는데요.

이 외에도 고대 박테리아는 세포를 다시 나눌 수 있는 능력이 있었고 재생산 능력을 지니고 있어 생존에 적합하지 않은 조건에서도 기능을 발휘할 수 있다고 합니다.

이에 놀란 과학자들 중 '아나톨리 박사'는 고대 박테리아가 영원한 젊음을 제공할 수 있다고 생각해 인간의 노화를 막을 수 있는 것을 연구하기 위해 직접 자신의 몸에 박테리아를 주입했다고 합니다.

그리고 그는 '생기와 에너지의 폭발을 느끼며 잔병치레가 사라졌다'며 자신이 이전보다 훨씬 나아졌다고 말하고 있는데요.

하지만 과학계는 이 박테리아가 동, 식물에 이롭게 작용하는 메커니즘이 제대로 확인되지 않았다고 보고 있다고 합니다.
과학계에서는 어떤 부작용이 일어날지 모르는 것에 우려하고 있지만 아나톨리 박사는 2013년에 고대 박테리아를 투여 후에도 아직도 멀쩡하게 잘 지내고 있다고 합니다.
▼베트남 다낭 커뮤니티 네이버 카페▼
